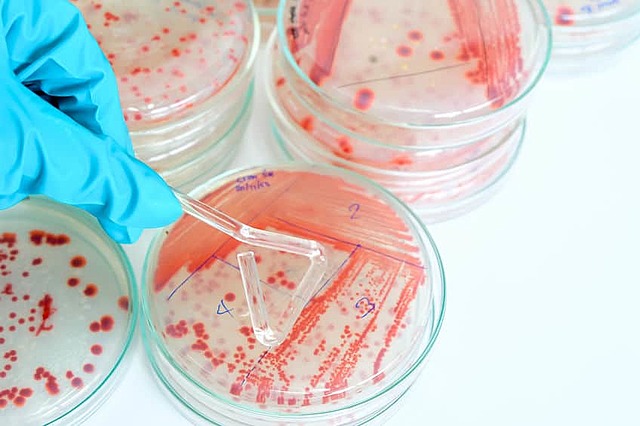
Microbiologia Moderna

-
El inicio de la microbiología esta aproximadamente desde la segunda mitas del siglo XIX, se podría decir que la primera persona al hablar de esto fue Teofrasto pero no está del todo garantizado puesto que el escribió volúmenes sobre las plantas toman una mini parte de lo que hoy se conoce como microbiología pero él lo vio desde las propiedades curativas de las plantas.
-
El creador oficial de la microbiología fue Antonie Van Leeuwenhoek, que era un fabricador de lentes visuales y con ese creo el microscopio de un solo lente en 1621 y con el cual descubrió mini partículas por medio de una gota de lluvia que estaba estancada y se dio cuenta de las pequeñas cosas que estaban flotando a su alrededor al momento de examinar.
-
La primera bacteria está relacionada con Antonie cuando examinó la gota de agua con su microscopio basado en el creador Robert Hooke, las minis partículas que encontró en un principio las llamó “animálculos”. Pero oficialmente las bacterias fueron introducidas en 1676 por Christian Gottfried Ehrenberg pero claramente por el descubrimiento de Antonie.
-
Es el estudio de los microorganismos y sus actividades. Esto concierne a su forma, estructura, fisiología, reproducción, metabolismo e identificación. El objetivo de la Microbiología es comprender las actividades perjudiciales y beneficiosas de los microorganismos y mediante esta comprensión, diseñar la manera de aumentar los beneficios y reducir o eliminar los daños.
-
Uno de los beneficios que nos trajo el descubrimiento de la microbióloga fue lo fácil de descubrir las enfermedades o el propósito de estas, puesto que antes una enfermedad atacaba sin avisar y esto nos perjudicaba, pero eso cambió hace 300 años que no teníamos conocimiento de esta ciencia.
-
A través de sus experimentos refutó definitivamente la teoría de la generación espontánea y desarrolló la teoría germinal de las enfermedades infecciosas y por eso es considerado el padre de la microbiología moderna.
-
Paso de Antoni Leeuwenhoek a Pasteur.
De un microscopio con un lente a la generación espontánea -
P.Ehrlich propone el concepto de balas mágicas (destruir lo infeccioso son hacer daño al humano)- relacionado con los beneficios
-
Destacados a la microbiología 2000 Arvid carlsson: transmisión sináptica y traducción.
2001 Leland H.: Control del ciclo celular
2004 Richard Alex: receptores olfatorios
2008 francoise: descubrimiento del VIH
2012 John B.: clonación animal, reprogramación celular -
Listeria costarricenses descubierta por los científicos de Costa Rica en compañía con los científicos del instituto Pasteur, la Listeria es un grupo de bacterias compuesto por 18 especies, dos de ellas son patógenas ( causan graves daños al ser humano y animales) y se adquieren tras consumir alimentos contaminados. Puede causar meningitis y a las mujeres embarazadas produce graves afectaciones al bebé incluyendo el aborto
Plan projects on a visual timeline
Map milestones, phases, deadlines, and key events in one place so the sequence is easier to see and share. Timetoast is a timeline maker for work, school, research, and stories.